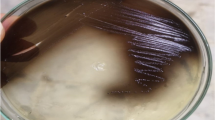

Abstract
Cholangiocarcinoma (CCA), a bile duct cancer with a high mortality rate, has a poor prognosis due to its highly invasive and drug-resistant phenotypes. More effective and selective therapies are urgently needed. Bacteriocins are broad-spectrum antimicrobial peptides/proteins produced by bacterial strains to compete with other bacteria. Recent studies have reported that bacteriocins exhibit anticancer properties against various cancer cell lines with minimal toxicity toward normal cells. In this study, two types of recombinant bacteriocins, rhamnosin from probiotic Lacticaseibacillus rhamnosus and lysostaphin from Staphylococcus simulans, were highly produced in Escherichia coli and subsequently purified via immobilized-Ni2+ affinity chromatography. When their anticancer activity was investigated against CCA cell lines, both rhamnosin and lysostaphin were found capable of inhibiting the growth of CCA cell lines in a dose-dependent fashion but were less toxic toward a normal cholangiocyte cell line. Rhamnosin and lysostaphin as single treatments could suppress the growth of gemcitabine-resistant cell lines to the same extent as or more than they suppressed the parental counterparts. A combination of both bacteriocins more strongly inhibited growth and enhanced cell apoptosis in both parental and gemcitabine-resistant cells partly through the increased expression of the proapoptotic genes BAX, and caspase-3, -8, and -9. In conclusion, this is the first report to demonstrate an anticancer property of rhamnosin and lysostaphin. Using these bacteriocins as single agents or in combination would be effective against drug-resistant CCA.







Similar content being viewed by others
Data Availability
The data used and/or analyzed during the current study are available from the corresponding author upon reasonable request.
References
Macias RIR (2014) Cholangiocarcinoma: biology, clinical management, and pharmacological perspectives. ISRN Hepatol 2014:828074. https://doi.org/10.1155/2014/828074
Banales JM, Marin JJG, Lamarca A et al (2020) Cholangiocarcinoma 2020: the next horizon in mechanisms and management. Nat Rev Gastroenterol Hepatol 17:557–588. https://doi.org/10.1038/s41575-020-0310-z
Bridgewater J, Galle PR, Khan SA et al (2014) Guidelines for the diagnosis and management of intrahepatic cholangiocarcinoma. J Hepatol 60:1268–1289. https://doi.org/10.1016/j.jhep.2014.01.021
Sripa B, Pairojkul C (2008) Cholangiocarcinoma: lessons from Thailand. Curr Opin Gastroenterol 24:349–356. https://doi.org/10.1097/MOG.0b013e3282fbf9b3
Lao L, Hope AJ, Maganti M et al (2014) Incidental prophylactic nodal irradiation and patterns of nodal relapse in inoperable early stage NSCLC patients treated with SBRT: a case-matched analysis. Int J Radiat Oncol Biol Phys 90:209–215. https://doi.org/10.1016/j.ijrobp.2014.05.006
Rami-Porta R, Bolejack V, Crowley J et al (2015) The IASLC lung cancer staging project: proposals for the revisions of the T descriptors in the forthcoming eighth edition of the TNM classification for lung cancer. J Thorac Oncol 10:990–1003. https://doi.org/10.1097/JTO.0000000000000559
Marin JJG, Briz O, Herraez E et al (2018) Molecular bases of the poor response of liver cancer to chemotherapy. Clin Res Hepatol Gastroenterol 42:182–192. https://doi.org/10.1016/j.clinre.2017.12.006
Kaur S, Kaur S (2015) Bacteriocins as potential anticancer agents. Front Pharmacol 6:272. https://doi.org/10.3389/fphar.2015.00272
Ahmadi S, Ghollasi M, Hosseini HM (2017) The apoptotic impact of nisin as a potent bacteriocin on the colon cancer cells. Microb Pathog 111:193–197. https://doi.org/10.1016/j.micpath.2017.08.037
Karpiński TM, Adamczak A (2018) Anticancer activity of bacterial proteins and peptides. Pharmaceutics 10:54. https://doi.org/10.3390/pharmaceutics10020054
Nes IF, Holo H (2000) Class II antimicrobial peptides from lactic acid bacteria. Biopolymers 55:50–61. https://doi.org/10.1002/1097-0282(2000)55:1%3c50::AID-BIP50%3e3.0.CO;2-3
Acuña L, Picariello G, Sesma F et al (2012) A new hybrid bacteriocin, Ent35-MccV, displays antimicrobial activity against pathogenic gram-positive and gram-negative bacteria. FEBS Open Bio 2:12–19. https://doi.org/10.1016/j.fob.2012.01.002
Klaenhammer TR (1988) Bacteriocins of lactic acid bacteria. Biochimie 70:337–349. https://doi.org/10.1016/0300-9084(88)90206-4
Silva CCG, Silva SPM, Ribeiro SC (2018) Application of bacteriocins and protective cultures in dairy food preservation. Front Microbiol 9:594. https://doi.org/10.3389/fmicb.2018.00594
Jeong Y-J, Moon G-S (2015) Antilisterial bacteriocin from Lactobacillus rhamnosus CJNU 0519 presenting a narrow antimicrobial spectrum. Korean J Food Sci Anim Resour 35:137–142. https://doi.org/10.5851/kosfa.2015.35.1.137
Jin Ng Z, Abu Zarin M, Keong Lee C, Shun Tan J (2020) Application of bacteriocins in food preservation and infectious disease treatment for humans and livestock: a review. RSC Adv 10:38937–38964. https://doi.org/10.1039/D0RA06161A
Nigam A, Gupta D, Sharma A (2014) Treatment of infectious disease: beyond antibiotics. Microbiol Res 169:643–651. https://doi.org/10.1016/j.micres.2014.02.009
Meade E, Slattery MA, Garvey M (2020) Bacteriocins, potent antimicrobial peptides and the fight against multi drug resistant species: resistance Is futile? Antibiotics (Basel) 9:32. https://doi.org/10.3390/antibiotics9010032
Abdi-Ali A, Worobec EA, Deezagi A, Malekzadeh F (2004) Cytotoxic effects of pyocin S2 produced by Pseudomonas aeruginosa on the growth of three human cell lines. Can J Microbiol 50:375–381. https://doi.org/10.1139/w04-019
Fathizadeh H, Saffari M, Esmaeili D et al (2021) Anticancer effect of enterocin A-colicin E1 fusion peptide on the gastric cancer cell. Probiotics Antimicrob Proteins 13:1443–1451. https://doi.org/10.1007/s12602-021-09770-y
Rezaei-Moshaei M, Dehestani A, Bandehagh A et al (2021) Recombinant pebulin protein, a type 2 ribosome-inactivating protein isolated from dwarf elder (Sambucus ebulus L.) shows anticancer and antifungal activities in vitro. Int J Biol Macromol 174:352–361. https://doi.org/10.1016/j.ijbiomac.2021.01.129
Sereena MC, Sebastian D (2020) Evaluation of anticancer and anti-hemolytic activity of azurin, a novel bacterial protein from Pseudomonas aeruginosa SSj. Int J Pept Res Ther 26:459–466. https://doi.org/10.1007/s10989-019-09851-1
Chumchalová J, Smarda J (2003) Human tumor cells are selectively inhibited by colicins. Folia Microbiol (Praha) 48:111–115. https://doi.org/10.1007/BF02931286
Simons A, Alhanout K, Duval RE (2020) Bacteriocins, antimicrobial peptides from bacterial origin: overview of their biology and their impact against multidrug-resistant bacteria. Microorganisms 8:639. https://doi.org/10.3390/microorganisms8050639
Cleveland J, Montville TJ, Nes IF, Chikindas ML (2001) Bacteriocins: safe, natural antimicrobials for food preservation. Int J Food Microbiol 71:1–20. https://doi.org/10.1016/S0168-1605(01)00560-8
Fernandes A, Jobby R (2022) Bacteriocins from lactic acid bacteria and their potential clinical applications. Appl Biochem Biotechnol 194:4377–4399. https://doi.org/10.1007/s12010-022-03870-3
Karpiński TM, Szkaradkiewicz AK (2016) Bacteriocins. In: Caballero B, Finglas PM, Toldrá F (eds) Encyclopedia of Food and Health. Academic Press, Oxford, pp 312–319
Oliveira LDC, Silveira AM, Monteiro ADS et al (2017) In silico prediction, in vitro antibacterial spectrum, and physicochemical properties of a putative bacteriocin produced by Lactobacillus rhamnosus strain L156. 4. Front Microbiol 8:876
Srinivasan R, Kumawat DK, Kumar S, Saxena AK (2013) Purification and characterization of a bacteriocin from Lactobacillus rhamnosus L34. Ann Microbiol 63:387–392. https://doi.org/10.1007/s13213-012-0486-8
Dimitrijević R, Stojanović M, Zivković I et al (2009) The identification of a low molecular mass bacteriocin, rhamnosin A, produced by Lactobacillus rhamnosus strain 68. J Appl Microbiol 107:2108–2115. https://doi.org/10.1111/j.1365-2672.2009.04539.x
Yue T, Pei J, Yuan Y (2013) Purification and characterization of anti-alicyclobacillus bacteriocin produced by Lactobacillus rhamnosus. J Food Prot 76:1575–1581. https://doi.org/10.4315/0362-028X.JFP-12-496
Zhou B, Zhang D (2018) Antibacterial effects of bacteriocins isolated from Lactobacillus rhamnosus (ATCC 53103) in a rabbit model of knee implant infection. Exp Ther Med 15:2985–2989. https://doi.org/10.3892/etm.2018.5790
Zimina M, Babich O, Prosekov A et al (2020) Overview of global trends in classification, methods of preparation and application of bacteriocins. Antibiotics 9:553. https://doi.org/10.3390/antibiotics9090553
Barraza DE, Ríos Colombo NS, Galván AE et al (2017) New insights into enterocin CRL35: mechanism of action and immunity revealed by heterologous expression in Escherichia coli. Mol Microbiol 105:922–933. https://doi.org/10.1111/mmi.13746
Yoneyama F, Imura Y, Ohno K et al (2009) Peptide-lipid huge toroidal pore, a new antimicrobial mechanism mediated by a Lactococcal Bacteriocin, lacticin Q. Antimicrob Agents Chemother 53:3211–3217. https://doi.org/10.1128/AAC.00209-09
Netz DJA, Pohl R, Beck-Sickinger AG et al (2002) Biochemical characterisation and genetic analysis of aureocin A53, a new, atypical bacteriocin from Staphylococcus aureus. J Mol Biol 319:745–756. https://doi.org/10.1016/S0022-2836(02)00368-6
van Belkum MJ, Kok J, Venema G et al (1991) The bacteriocin lactococcin A specifically increases permeability of lactococcal cytoplasmic membranes in a voltage-independent, protein-mediated manner. J Bacteriol. https://doi.org/10.1128/jb.173.24.7934-7941.1991
Sand SL, Haug TM, Nissen-Meyer J, Sand O (2007) The bacterial peptide pheromone plantaricin A permeabilizes cancerous, but not normal, rat pituitary cells and differentiates between the outer and inner membrane leaflet. J Membr Biol 216:61–71. https://doi.org/10.1007/s00232-007-9030-3
Hetz C, Bono MR, Barros LF, Lagos R (2002) Microcin E492, a channel-forming bacteriocin from Klebsiella pneumoniae, induces apoptosis in some human cell lines. PNAS 99:2696–2701. https://doi.org/10.1073/pnas.052709699
Bastos M, do C de F, Coutinho BG, Coelho MLV (2010) Lysostaphin: a staphylococcal bacteriolysin with potential clinical applications. Pharmaceuticals 3:1139–1161. https://doi.org/10.3390/ph3041139
Sripa B, Leungwattanawanit S, Nitta T et al (2005) Establishment and characterization of an opisthorchiasis-associated cholangiocarcinoma cell line (KKU-100). World J Gastroenterol 11:3392–3397. https://doi.org/10.3748/wjg.v11.i22.3392
Maruyama M, Kobayashi N, Westerman KA et al (2004) Establishment of a highly differentiated immortalized human cholangiocyte cell line with SV40T and hTERT. Transplantation 77:446–451. https://doi.org/10.1097/01.TP.0000110292.73873.25
Govindan SV, Kulsum S, Pandian RS et al (2015) Establishment and characterization of triple drug resistant head and neck squamous cell carcinoma cell lines. Mol Med Rep 12:3025–3032. https://doi.org/10.3892/mmr.2015.3768
Klinhom-On N, Seubwai W, Sawanyawisuth K et al (2021) FOXM1 inhibitor, siomycin A, synergizes and restores 5-FU cytotoxicity in human cholangiocarcinoma cell lines via targeting thymidylate synthase. Life Sci 286:120072. https://doi.org/10.1016/j.lfs.2021.120072
Morita H, Toh H, Oshima K et al (2009) Complete genome sequence of the probiotic Lactobacillus rhamnosus ATCC 53103. J Bacteriol 191:7630–7631. https://doi.org/10.1128/JB.01287-09
Ojha SC, Imtong C, Meetum K et al (2018) Purification and characterization of the antibacterial peptidase lysostaphin from Staphylococcus simulans: adverse influence of Zn2+ on bacteriolytic activity. Protein Expr Purif 151:106–112. https://doi.org/10.1016/j.pep.2018.06.013
Du Z, Su H, Wang W et al (2021) The trRosetta server for fast and accurate protein structure prediction. Nat Protoc 16:5634–5651. https://doi.org/10.1038/s41596-021-00628-9
Sabala I, Jagielska E, Bardelang PT et al (2014) Crystal structure of the antimicrobial peptidase lysostaphin from Staphylococcus simulans. FEBS J 281:4112–4122. https://doi.org/10.1111/febs.12929
Friedman R (2016) Drug resistance in cancer: molecular evolution and compensatory proliferation. Oncotarget 7:11746. https://doi.org/10.18632/oncotarget.7459
Baindara P, Korpole S, Grover V (2018) Bacteriocins: perspective for the development of novel anticancer drugs. Appl Microbiol Biotechnol. https://doi.org/10.1007/s00253-018-9420-8
Warso MA, Richards JM, Mehta D et al (2013) A first-in-class, first-in-human, phase I trial of p28, a non-HDM2-mediated peptide inhibitor of p53 ubiquitination in patients with advanced solid tumours. Br J Cancer 108:1061–1070. https://doi.org/10.1038/bjc.2013.74
Lagos R, Tello M, Mercado G et al (2009) Antibacterial and antitumorigenic properties of microcin E492, a pore-forming bacteriocin. Curr Pharm Biotechnol 10:74–85. https://doi.org/10.2174/138920109787048643
Villarante KI, Elegado FB, Iwatani S et al (2011) Purification, characterization and in vitro cytotoxicity of the bacteriocin from Pediococcus acidilactici K2a2-3 against human colon adenocarcinoma (HT29) and human cervical carcinoma (HeLa) cells. World J Microbiol Biotechnol 27:975–980. https://doi.org/10.1007/s11274-010-0541-1
Farkas-Himsley H (1988) Sensitivity of various malignant cell lines to partially purified bacteriocins: inherent and proliferative dependence. Microbios letters 39:57–66
Sand SL, Nissen-Meyer J, Sand O, Haug TM (2013) Plantaricin A, a cationic peptide produced by Lactobacillus plantarum, permeabilizes eukaryotic cell membranes by a mechanism dependent on negative surface charge linked to glycosylated membrane proteins. Biochim Biophys Acta 1828:249–259. https://doi.org/10.1016/j.bbamem.2012.11.001
Carolissen-Mackay V, Arendse G, Hastings JW (1997) Purification of bacteriocins of lactic acid bacteria: problems and pointers. Int J Food Microbiol 34:1–16. https://doi.org/10.1016/S0168-1605(96)01167-1
Rodrı́guez JM, Martı́nez MI, Horn N, Dodd HM (2003) Heterologous production of bacteriocins by lactic acid bacteria. Int J Food Microbiol 80:101–116. https://doi.org/10.1016/S0168-1605(02)00153-8
Lohans CT, Vederas JC (2011) Development of class IIa bacteriocins as therapeutic agents. Int J Microbiol 2012:e386410. https://doi.org/10.1155/2012/386410
Gutiérrez J, Criado R, Citti R et al (2005) Cloning, production and functional expression of enterocin P, a sec-dependent bacteriocin produced by Enterococcus faecium P13, in Escherichia coli. Int J Food Microbiol 103:239–250. https://doi.org/10.1016/j.ijfoodmicro.2004.11.035
Ingham AB, Sproat KW, Tizard MLV, Moore RJ (2005) A versatile system for the expression of nonmodified bacteriocins in Escherichia coli. J Appl Microbiol 98:676–683. https://doi.org/10.1111/j.1365-2672.2004.02502.x
Moon G-S, Pyun Y-R, Kim WJ (2006) Expression and purification of a fusion-typed pediocin PA-1 in Escherichia coli and recovery of biologically active pediocin PA-1. Int J Food Microbiol 108:136–140. https://doi.org/10.1016/j.ijfoodmicro.2005.10.019
Masias RE, Picariello G, Acuña L et al (2014) Co-expression and characterization of enterocin CRL35 and its mutant in Escherichia coli Rosetta. De Gruyter. https://doi.org/10.2478/ped-2014-0003
Mesa-Pereira B, O’Connor PM, Rea MC et al (2017) Controlled functional expression of the bacteriocins pediocin PA-1 and bactofencin A in Escherichia coli. Sci Rep 7:3069. https://doi.org/10.1038/s41598-017-02868-w
Mesa-Pereira B, Rea MC, Cotter PD et al (2018) Heterologous expression of biopreservative bacteriocins with a view to low cost production. Front Microbiol 9: 1645. https://doi.org/10.3389/fmicb.2018.01654
Sloan GL, Smith EC, Lancaster JH (1977) Lysostaphin endopeptidase-catalysed transpeptidation reactions of the imino-transfer type. Biochem J 167:293–296. https://doi.org/10.1042/bj1670293
Utsugi T, Schroit AJ, Connor J et al (1991) Elevated expression of phosphatidylserine in the outer membrane leaflet of human tumor cells and recognition by activated human blood monocytes. Cancer Res 51:3062–3066
Schweizer F (2009) Cationic amphiphilic peptides with cancer-selective toxicity. Eur J Pharmacol 625:190–194. https://doi.org/10.1016/j.ejphar.2009.08.043
Riedl S, Rinner B, Asslaber M et al (2011) In search of a novel target — phosphatidylserine exposed by non-apoptotic tumor cells and metastases of malignancies with poor treatment efficacy. Biochim Biophys Acta 1808:2638–2645. https://doi.org/10.1016/j.bbamem.2011.07.026
Dobrzyńska I, Szachowicz-Petelska B, Sulkowski S, Figaszewski Z (2005) Changes in electric charge and phospholipids composition in human colorectal cancer cells. Mol Cell Biochem 276:113–119. https://doi.org/10.1007/s11010-005-3557-3
Hoskin DW, Ramamoorthy A (2008) Studies on anticancer activities of antimicrobial peptides. Biochim Biophys Acta 1778:357–375. https://doi.org/10.1016/j.bbamem.2007.11.008
Sok M, Sentjurc M, Schara M (1999) Membrane fluidity characteristics of human lung cancer. Cancer Lett 139:215–220. https://doi.org/10.1016/s0304-3835(99)00044-0
Chaudhary J, Munshi M (1995) Scanning electron microscopic analysis of breast aspirates. Cytopathology 6:162–167. https://doi.org/10.1111/j.1365-2303.1995.tb00469.x
Chan SC, Hui L, Chen HM (1998) Enhancement of the cytolytic effect of anti-bacterial cecropin by the microvilli of cancer cells. Anticancer Res 18:4467–4474
Chan SC, Yau WL, Wang W et al (1998) Microscopic observations of the different morphological changes caused by anti-bacterial peptides on Klebsiella pneumoniae and HL-60 leukemia cells. J Pept Sci 4:413–425. https://doi.org/10.1002/(SICI)1099-1387(199811)4:7%3c413::AID-PSC160%3e3.0.CO;2-W
Jia L, Gorman GS, Coward LU et al (2011) Preclinical pharmacokinetics, metabolism, and toxicity of azurin-p28 (NSC745104) a peptide inhibitor of p53 ubiquitination. Cancer Chemother Pharmacol 68:513–524. https://doi.org/10.1007/s00280-010-1518-3
Chakrabarty AM (2016) Bacterial azurin in potential cancer therapy. Cell Cycle 15:1665–1666. https://doi.org/10.1080/15384101.2016.1179034
Yamada T, Das Gupta TK, Beattie CW (2016) p28-mediated activation of p53 in G2–M phase of the cell cycle enhances the efficacy of DNA damaging and antimitotic chemotherapy. Cancer Res 76:2354–2365. https://doi.org/10.1158/0008-5472.CAN-15-2355
Acknowledgements
The authors would like to thank Thomas Duncan Coyne, Faculty of Science, Prince of Songkla University, Hatyai, Songkhla, Thailand for assistance with the English editing.
Funding
This work was supported by the National Science, Research and Innovation Fund (NSRF) and Prince of Songkla University (Grant No. SCI6505045S) to Sumalee Obchoei. Kankamol Kerdkumthong was supported by a Prince of Songkla University-Ph.D. Scholarship (PSU_PHD2561-001) and Thesis Research Grant from the Graduate School of Prince of Songkla University. Phonprapavee Tantimetta was supported by a Prince of Songkla University-Ph.D. Scholarship (PSU_PHD2565-002). Sutthipong Nanarong, and Kawinnath Songsurin were supported by a Thesis Research Grant from the Graduate School of Prince of Songkla University.
Author information
Authors and Affiliations
Contributions
Sumalee Obchoei, Aratee Aroonkesorn and Kankamol Kerdkumthong contributed to the study conception and design. Kankamol Kerdkumthong, Wannarat Chanket, Sutthipong Nanarong and Phonprapavee Tantimetta carried out the experiments and collected that data. Kawinnath Songsurin established the drug-resistant cell lines. Sumalee Obchoei, Aratee Aroonkesorn, Phanthipha Runsaeng, Kankamol Kerdkumthong and Wannarat Chanket performed data analysis. Chanan Angsuthanasombat was the senior supervisor. The first draft of the manuscript was written by Sumalee Obchoei and Kankamol Kerdkumthong and all authors commented on previous versions of the manuscript. All authors read and approved the final manuscript.
Corresponding author
Ethics declarations
Conflict of Interest
The authors declare no competing interests.
Additional information
Publisher's Note
Springer Nature remains neutral with regard to jurisdictional claims in published maps and institutional affiliations.
Rights and permissions
Springer Nature or its licensor (e.g. a society or other partner) holds exclusive rights to this article under a publishing agreement with the author(s) or other rightsholder(s); author self-archiving of the accepted manuscript version of this article is solely governed by the terms of such publishing agreement and applicable law.
About this article
Cite this article
Kerdkumthong, K., Chanket, W., Runsaeng, P. et al. Two Recombinant Bacteriocins, Rhamnosin and Lysostaphin, Show Synergistic Anticancer Activity Against Gemcitabine-Resistant Cholangiocarcinoma Cell Lines. Probiotics & Antimicro. Prot. 16, 713–725 (2024). https://doi.org/10.1007/s12602-023-10096-0
Accepted:
Published:
Issue Date:
DOI: https://doi.org/10.1007/s12602-023-10096-0